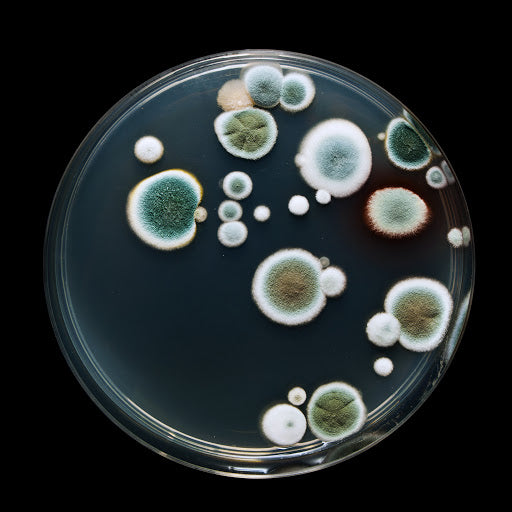
Mold and Yeast

harmonyvials
Mold and Yeast
Couldn't load pickup availability
Mold & Yeast:
1. Absidia Corymbifera
2. Acremonium
3. Alternaria
4. Apophysomy. Elegans
5. Arthrographis Kalrae
6. Aspergillus Flavus
7. Aspergillus Fumigatus
8. Aspergillus Nidulans
9. Aspergillus Niger
10. Aspergillus Versicolor
11. Aureobasid. Pullulans
12. Basidiobo. Ranarum
13. Bipolaris Spicifera
14. Bipolaris Hawaiiensis
15. Blastom. Dermatitidis
16. Blastoschi. Capitatus
17. Candida Albicans
18. Candida Dubliniensis
19. Candida Glabrata
20. Candida Guilliermond
21. Candida Krusei
22. Candida Lipolytica
23. Candida Lusitaniae
24. Candida Kefyr
25. Candida Parapsilosis
26. Candida Rugosa
27. Candida Tropicalis
28. Chaetom. Globosum
29. Chrysos. Tropicum
30. Cladospor. Herbarum
31. Cladospor. Sphaero.
32. Clados. Cladosporio.
33. Cladophial. Bantiana
34. Coccidioides Immitis
35. Conidiobolus Coron.
36. Cryptococcus Neo.
37. Cunninghamel. Berth.
38. Curvularia Lunata
39. Emmon. Pa. Va. Cres.
40. Epidermophyton Floc.
41. Exophiala Jeanselmei
42. Fonsecaea Compacta
43. Fusarium Solani
44. Geotrich. Candidum
45. Histoplasma Capsul.
46. Lacazia Loboi
47. Madurella Myceto.
48. Malassezia Furfur
49. Microsporum Audou.
50. Microsporum Canis
51. Mucor Indicus
52. Paecilomyces Variotii
53. Paracoccidioid. Bras.
54. Penicillium Marneffei
55. Phoma
56. Piedraia Hortae
57. Pseudallescheria Bo.
58. Rhizomucor
59. Rhizopus Oryzae
60. Rhodotorula Rubra
61. Saccharomyces Cer.
62. Scopulariops. Brevic.
63. Sporobolom. Salmon
64. Sporothrix Schenckii
65. Stemphylium Macro.
66. Streptomyces
67. Trichosporon Asahii
68. Trichospo. Cutaneum
69. Trichophy. Mentagro.
70. Trichophyton Rubrum
71. Trichophyton Schoen.
72. Trichophy. Tonsurans
73. Trichophy. Verrucos.
74. Trichophy Violaceum
75. Wangiella Dermatitid.
Care Instructions
Care Instructions
To preserve the Electromagnetic Signatures, do not expose vials to direct sunlight for more than 2-3 minutes, and do not leave them in a direct UV source.
The thermal paper of the labels don't respond well to adhesives. Please do not use tape, sticky notes, etc. on the labels as it will cause fading and deterioration.
-
Free Shipping
Free shipping is available on domestic orders over $299
-
Individually Labled Vials
Each vial comes individually labeled for your convenience